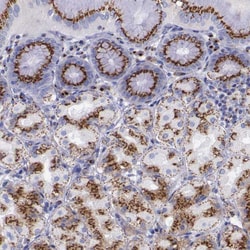
Invitrogen GOLGA5 Polyclonal Antibody 100 &mu;L; Unconjugated:Antibodies,

Learn More
Invitrogen™ GOLGA5 Polyclonal Antibody


Rabbit Polyclonal Antibody
Supplier: Invitrogen™ PA551495
Description
Immunogen sequence: SSVNPSVTTI KTIEENSFGS QTHEAASNSD SSHEGQEESS KENVSSNAAC PDHTPTPNDD GKSHELSNLR LENQLLRNEV QSLNQEMASL LQRSKETQEE LNKARARVEK WNADHSKSDR MTRGLRAQVD DLTEAVAAKD SQLAVLKV Highest antigen sequence identity to the following orthologs: Mouse - 70%, Rat - 76%.
The Golgi apparatus, which participates in glycosylation and transport of proteins and lipids in the secretory pathway, consists of a series of stacked cisternae (flattened membrane sacs). Interactions between the Golgi and microtubules are thought to be important for the reorganization of the Golgi after it fragments during mitosis. This gene encodes a member of the golgin family of proteins, whose members localize to the Golgi. This protein is a coiled-coil membrane protein that has been postulated to play a role in vesicle tethering and docking. Translocations involving this gene and the ret proto-oncogene have been found in tumor tissues; the chimeric sequences have been designated RET-II and PTC5.
Specifications
| GOLGA5 | |
| Polyclonal | |
| Unconjugated | |
| GOLGA5 | |
| Cell proliferation-inducing gene 31 protein; GOLGA5; golgi autoantigen, golgin subfamily a, 5; golgi integral membrane protein 5; golgin A5; Golgin subfamily A member 5; Golgin-84; GOLIM5; PIG31; Protein Ret-II; Protein Sumiko; RET-fused gene 5; RET-fused gene 5 protein; RETII; ret-II; RFG5 | |
| Rabbit | |
| Antigen affinity chromatography | |
| RUO | |
| 9950 | |
| Store at 4°C short term. For long term storage, store at -20°C, avoiding freeze/thaw cycles. | |
| Liquid |
| Immunohistochemistry (Paraffin), Western Blot, Immunocytochemistry | |
| 0.1 mg/mL | |
| PBS with 40% glycerol and 0.02% sodium azide; pH 7.2 | |
| Q8TBA6 | |
| GOLGA5 | |
| Recombinant protein corresponding to Human GOLGA5. Recombinant protein control fragment (Product #RP-88874). | |
| 100 μL | |
| Primary | |
| Human | |
| Antibody | |
| IgG |
Your input is important to us. Please complete this form to provide feedback related to the content on this product.